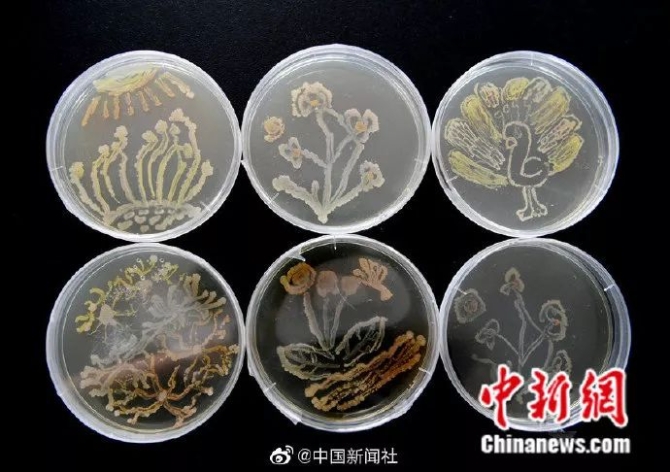

大学生
一个富有青春、活力的名词
大学生活
丰富多彩、千姿百态
什么是真正的大学生?
他们,有想法
从2017年9月起
哈尔滨师范大学的学生梁家进
历经背包行、自驾、“摩旅”等多种方式
拍摄旅行电影
终于在2019年7月彻底完成作品

图片来源:中新视频截图
“这一路来最大的收获就是
知道了自己真正热爱的是什么。
我想用镜头继续记录
生活的美好和大自然的神奇。”
他们,爱挑战
2019年暑期学校一放假
大三学生周浩便从三亚出发
一路骑行万里到达河北石家庄
途径广东、福建、江西、安徽等省份
算上2017、2018年暑假的骑行里程
周浩已自驾摩托车游历中国28个省份
总行程近4万公里
“我们不能拥有全世界,
但是我们可以去看遍全世界。”

他们,爱玩爱闹,也爱创造
马海龙是山西晋中的一名大学生
从小喜欢画画、建筑
高二时尝试在游戏中建造自己的学校
耗时3年,母校的
操场、教学楼、科技楼、广场等
均得到完美呈现

他们,有无限的想象与创造力
长春医学高等专科学校的学生们
以空气中的细菌为墨
以培养基为画布
创作出一批“细菌画”
绘画完成后需在37℃恒温条件下
培养24小时
形成菌苔后,“细菌画”才会显现
同学们介绍
这种不确定性让细菌画充满魅力
他们,会在有需要时挺身而出
一对大学情侣在河边散步时
听见有人喊:“一位小姑娘落水了!”
男孩第一时间冲向前去
和路人一起将孩子打捞上来
而学护理的女友
当即跪在地上对小姑娘做了心肺复苏等
救人过程中,男孩的手机不慎丢失
但这对小情侣并没有因此而感到沮丧
“一个手机算什么,
我们救的是一条人命!”

他们,有家庭的责任与担当
从大一开始
扬州大学2016级学生李东明
就边上学边打工
每月给父母寄去生活费,挑起家庭重担
今年上半年
照顾父母生活起居的姑姑去世
他将患有精神疾病的母亲和残疾父亲
接到身边照顾
“总是靠别人,
也总归只能解决一时。”

他们,有时候会很“傻”
河南商丘工学院
大一女生小曲和室友在寝室就地取材
用被子、娃娃扮演狮子
脸盆衣服即兴伴奏
在宿舍上演“舞狮”
“不在乎别人评论,
当代大学生活就是要多姿多彩。”

他们,会共同进步,共同成长
河北地质大学资源学院的一个女生宿舍
全宿舍9名女生中
有8人考上
北京大学、中国地质大学、中国科学院
等名校或国家重点科研机构研究生

他们
是祖国的未来与希望
然而这些
仅仅是冰山一角……
一位网友表示
“上大学就轻松了。”是老师骗你的
“上了大学就能找对象了。”是妈妈骗你的
考试周之前没日没夜地学习
各种作业,投票,活动才是常态
宿舍,教室,食堂,图书馆
是最常出没的地方
有时候也偷偷想家
然而即便是这样
大学时光
仍然是最值得每个人怀念的
初时不经意
一回头
却发现这是最好的时光
你的大学时光
是怎样度过的?
还记得那些年
你的那些神奇室友吗?
和小编分享你的大学经历
无奋斗,不青春!